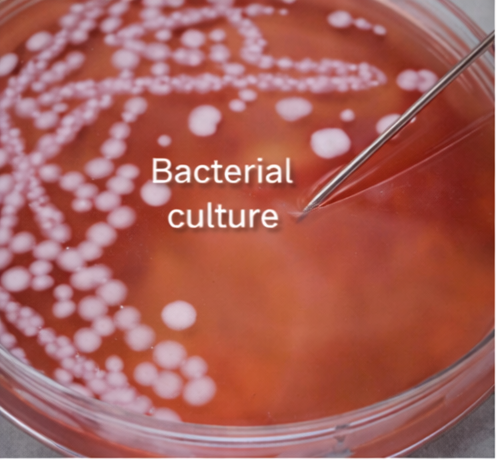

The minimum inhibitory concentration (MIC) is defined as the lowest concentration of an antimicrobial agent that prevents visible growth of a microorganism after a specified incubation period. MIC testing plays a critical role in guiding antimicrobial therapy, particularly in the era of rising antimicrobial resistance. We report a case of a hospitalized patient with a culture-proven bacterial infection in whom MIC-guided antimicrobial selection was essential for effective clinical management. This case highlights the clinical relevance of MIC interpretation in optimizing antibiotic choice, ensuring therapeutic efficacy, and limiting unnecessary exposure to ineffective agents.
Antimicrobial resistance poses a significant challenge to modern clinical practice, necessitating precise and evidence-based selection of antibiotic therapy. While qualitative susceptibility testing categorizes organisms as susceptible, intermediate, or resistant, quantitative methods such as minimum inhibitory concentration determination provide a more nuanced assessment of antimicrobial activity [1].
The MIC represents the lowest concentration of an antimicrobial agent capable of inhibiting visible microbial growth under standardized laboratory conditions. It serves as a cornerstone for antimicrobial susceptibility testing and is particularly valuable in managing severe infections, infections caused by multidrug-resistant organisms, and cases where treatment failure is suspected [2]. This case report illustrates the application of MIC testing in clinical decision-making and underscores its importance in individualized patient care.
A 56-year-old man was admitted to the medical ward with a five-day history of high-grade fever, dysuria, increased urinary frequency, and lower abdominal discomfort. His medical history was significant for long-standing type 2 diabetes mellitus and multiple episodes of recurrent urinary tract infections over several years.

He had received multiple courses of empirical broad-spectrum antibiotics during the past year, raising concern for possible antimicrobial resistance.
On admission, the patient was febrile with a recorded temperature of 38.8°C and was tachycardic, though his blood pressure remained stable. Abdominal examination revealed mild suprapubic tenderness without guarding or rigidity. There were no clinical features suggestive of systemic sepsis, septic shock, or organ dysfunction, and the remainder of the systemic examination was unremarkable.
Laboratory investigations revealed significant leukocytosis with neutrophilic predominance, along with elevated inflammatory markers, supporting an underlying acute bacterial infection.

Urinalysis demonstrated marked pyuria and bacteriuria, consistent with an active urinary tract infection. Blood cultures remained sterile, indicating the absence of hematogenous spread, while urine culture isolated a Gram-negative bacillus subsequently identified as Escherichia coli.
In view of the patient’s history of recurrent urinary tract infections and repeated exposure to empirical antibiotic therapy, there was a high index of suspicion for antimicrobial resistance. Consequently, detailed antimicrobial susceptibility testing, including determination of minimum inhibitory concentrations, was requested to enable precise, targeted antimicrobial selection and optimize clinical management.
Antimicrobial susceptibility testing was conducted using a standardized broth microdilution method in accordance with accepted laboratory guidelines. The minimum inhibitory concentration was defined as the lowest concentration of each tested antimicrobial agent that prevented visible bacterial growth after overnight incubation under controlled conditions. This quantitative approach allowed precise assessment of the organism’s antimicrobial response profile.
The bacterial isolate demonstrated elevated MIC values for several commonly prescribed first-line agents, including fluoroquinolones and third-generation cephalosporins, consistent with a resistant phenotype and prior antibiotic exposure. In contrast, the MIC values for piperacillin–tazobactam and carbapenems remained within the susceptible range based on established clinical breakpoints, indicating preserved activity of these agents and supporting their selection for targeted, MIC-guided therapy.
Based on microbiological culture findings and comprehensive MIC interpretation, the patient was diagnosed with a complicated urinary tract infection caused by a multidrug-resistant Escherichia coli strain. The isolate exhibited resistance to multiple commonly prescribed first-line antimicrobial agents, reflecting prior antibiotic exposure and selective pressure. However, susceptibility was preserved to selected higher-tier antimicrobials with favorable MIC values, enabling precise, MIC-guided selection of effective therapy and avoidance of inappropriate or suboptimal antibiotic use.
Empirical antibiotic therapy was promptly discontinued once definitive microbiological and MIC data became available, and antimicrobial treatment was individualized based on the susceptibility profile of the isolated organism. The patient was initiated on intravenous piperacillin–tazobactam at an optimized, weight- and severity-adjusted dose to ensure sustained drug concentrations above the MIC for the infecting pathogen, in accordance with pharmacokinetic and pharmacodynamic principles.

Within 72 hours of initiating targeted therapy, the patient showed marked clinical improvement, with complete resolution of fever and significant reduction in urinary symptoms. Serial laboratory investigations demonstrated normalization of leukocyte counts and inflammatory markers, indicating effective infection control. A repeat urine culture obtained after completion of the antibiotic course was sterile, confirming microbiological eradication. The patient was subsequently discharged in stable clinical condition with clear follow-up instructions and counseling on infection prevention and glycemic control.

MIC determination provides quantitative data that enhances the clinical utility of antimicrobial susceptibility testing. Unlike categorical susceptibility results alone, MIC values allow clinicians to assess the degree of susceptibility and optimize dosing strategies, particularly in severe or refractory infections [3].
In this case, MIC testing was instrumental in identifying effective antimicrobial options despite resistance to commonly prescribed agents. Knowledge of the MIC enabled selection of an antibiotic with reliable activity against the pathogen, contributing to rapid clinical resolution. Furthermore, MIC-guided therapy supports antimicrobial stewardship by minimizing unnecessary use of broad-spectrum agents and reducing the risk of further resistance development [4].
The case also underscores the importance of integrating laboratory data with clinical context. Factors such as infection site, host immunity, pharmacokinetics, and pharmacodynamics must be considered alongside MIC values to ensure optimal therapeutic outcomes.
The minimum inhibitory concentration represents the lowest drug concentration that prevents visible microbial growth and serves as a critical parameter in antimicrobial susceptibility testing. This case highlights the practical clinical value of MIC determination in guiding targeted antibiotic therapy, particularly in infections caused by multidrug-resistant organisms.
Accurate interpretation of MIC results facilitates informed antimicrobial selection, optimizes treatment efficacy, and supports responsible antibiotic use. Incorporating MIC-based decision-making into routine clinical practice remains essential for improving patient outcomes and combating the growing threat of antimicrobial resistance.
Read more such content on @ Hidoc Dr | Medical Learning App for Doctors
1.
Potential new therapy for childhood brain cancer could heal treatment-resistant tumors
2.
Investigating the Relationship Between GERD and Anxiety/Depression.
3.
In a clinical trial, "3D mammography" nearly reduces the incidence of breast cancer between two screening exams.
4.
Indoor hydroponic gardening can improve mental health and quality of life for cancer patients
5.
Dr. Prerana S. Nesargi's message for Childhood Cancer Awareness Month 2023 is to increase understanding of pediatric oncology.
1.
How AI, Multi-Omics, and Real-World Evidence are Redefining Oncology Research and Shaping Cancer Care?
2.
Value, Access, and Affordability in Next-Gen Oncology: Navigating Costs, Coverage, and Clinical Impact
3.
Vaccines that can help prevent cancer
4.
Innovative Strategies in Prostate Cancer Management: From Surveillance to Systemic Therapies
5.
Revolutionizing Cancer Treatment: Harnessing the Power of AI in Histopathology
1.
International Lung Cancer Congress®
2.
Genito-Urinary Oncology Summit 2026
3.
Future NRG Oncology Meeting
4.
ISMB 2026 (Intelligent Systems for Molecular Biology)
5.
Annual International Congress on the Future of Breast Cancer East
1.
Molecular Contrast: EGFR Axon 19 vs. Exon 21 Mutations - Part I
2.
ESMO Breast Cancer 2022: P Reality X- A Restrospective Analysis
3.
A Comprehensive Guide to First Line Management of ALK Positive Lung Cancer - Part VI
4.
First Line Combination Therapy- The Overall Survival Data in NSCLC Patients
5.
Evolving Space of First-Line Treatment for Urothelial Carcinoma- Case Discussion
© Copyright 2026 Hidoc Dr. Inc.
Terms & Conditions - LLP | Inc. | Privacy Policy - LLP | Inc. | Account Deactivation